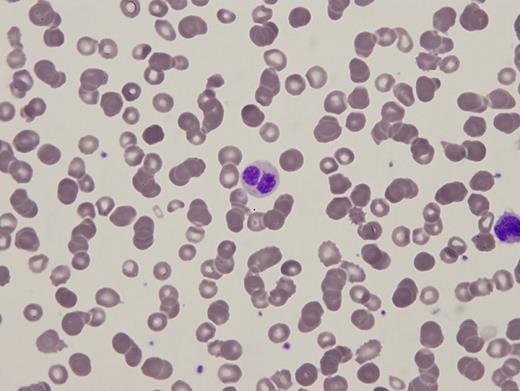

A 68-year-old man with a history of polycystic kidney disease presented five months postcadaveric renal transplantation with new-onset neutropenia and anemia, as well as a rising creatinine (2.59 mg/dL the prior week) with no other significant symptoms. A concurrent complete blood count showed the following:
White blood cell count 2.25 K/μL (absolute neutrophil count 0.71 K/μL)Hemoglobin7.9 g/dLHematocrit24.9%Mean corpuscular volume86.2 fLPlatelet count160 K/μL.
A 95-gene next-generation sequencing myeloid panel identified no pathogenic variants or copy number alterations. Metaphase cytogenetics revealed a normal karyotype. Two images from the peripheral blood smear and one image of the bone marrow biopsy are shown in Figures 1 and 2.
Peripheral blood smear
Peripheral blood smear
Bone marrow biopsy
A. Congenital Pelger-Huët anomaly
B. Infection
C. Myelodysplastic syndrome
D. Medication (mycophenolate mofetil/tacrolimus)
E. Autoimmune disorder
Sorry, that was not the preferred response.
Correct!
Pelger-Huët anomaly (PHA) is a constitutional disorder that can be caused by several germline lamin B receptor (LBR) mutations resulting in variable deficiency of the receptor. In heterozygous cases, the majority of neutrophils are bilobed, with two equal-sized nuclear lobes connected by a thin filament (Figure 1A). Rare homozygous cases may be more strikingly unilobed or indented (Stodtmeister cells, see Figure 1B) and associated with other constitutional syndromes. Congenital PHA should be distinguished from pseudo-PHA (PPHA), which can be an acquired marker of a variety of conditions including hematopoietic malignancies (such as myelodysplastic syndrome), sepsis/leukemoid reaction, autoimmune disorders, and drug-effects.1 The diagnosis is made by integration of clinical, laboratory, morphologic, cytogenetic, and molecular findings.
In this case, the patient presented with peripheral cytopenia only following renal transplantation while on mycophenolate mofetil and tacrolimus (MMF/TAC) for immunosuppression. Congenital PHA and autoimmune disorders (options A and E, respectively) are highly unlikely with this clinical presentation. Leukopenia and PPHA caused by infection (option B) is possible, especially in the setting of immunosuppression. However, there was no evidence of infection after clinical investigation. A bone marrow biopsy and aspiration revealed a hypocellular marrow with myeloid hypoplasia (Figure 2). MMF/TAC have been reported to cause PPHA with concurrent neutropenia and myeloid hypoplasia, with the degree of hypolobation correlated with the degree of neutropenia. This may be more severe in patients also on ganciclovir. Thus, this patient's neutropenia is likely due to an iatrogenic drug effect. The patient's anemia may be due to his renal dysfunction. Given these possible etiologies for the patient's cytopenias, there is insufficient evidence for a myelodysplastic syndrome (MDS). Furthermore, cytogenetic and molecular diagnostic (next generation sequencing-based assay) tests failed to reveal any chromosomal or molecular abnormalities commonly associated with a clonal myeloid neoplasm, thus making the diagnosis of MDS (option C) unlikely. Therefore, reactive PPHA secondary to immunosuppressive agents MMF/TAC (option D) is the most plausible explanation in this clinical scenario.
MMF/TAC-induced PPHA is a well-recognized phenomenon and often presents with cytopenia shortly after commencing immunosuppressive agents.2,3 A synergistic effect between MMF and TAC, and potentially ganciclovir, has been reported and supports a possible interaction between these drugs.3 The mechanisms of these morphologic changes have not been elucidated. However, several hypotheses, including reversible inhibition of inosine monophosphate dehydrogenase and reduction of LBR protein expression, have been proposed.2,3 The most important differential diagnosis to exclude is MDS, as it has significant clinical implications affecting prognosis and treatment. A careful clinical history including review of medications must be sought. Examination of the peripheral blood smear and bone marrow biopsy can reveal morphologic clues. For example, in contrast to MDS, drug-induced PPHA has a higher proportion of abnormal neutrophils with an absence of dysplasia in other lineages, hypo-to-normocellular marrow, no increase in blast count, and an absence of acquired clonal cytogenetic or molecular aberrations.2 In the appropriate clinical scenario of allogenic transplantation with immunosuppression, these findings should suggest a diagnosis of drug-induced PPHA which may be confirmed by restoration of normal neutrophil numbers and morphology upon discontinuation of the responsible drugs.3
References
References
Dr. Li and Dr. Kim indicated no relevant conflicts of interest.